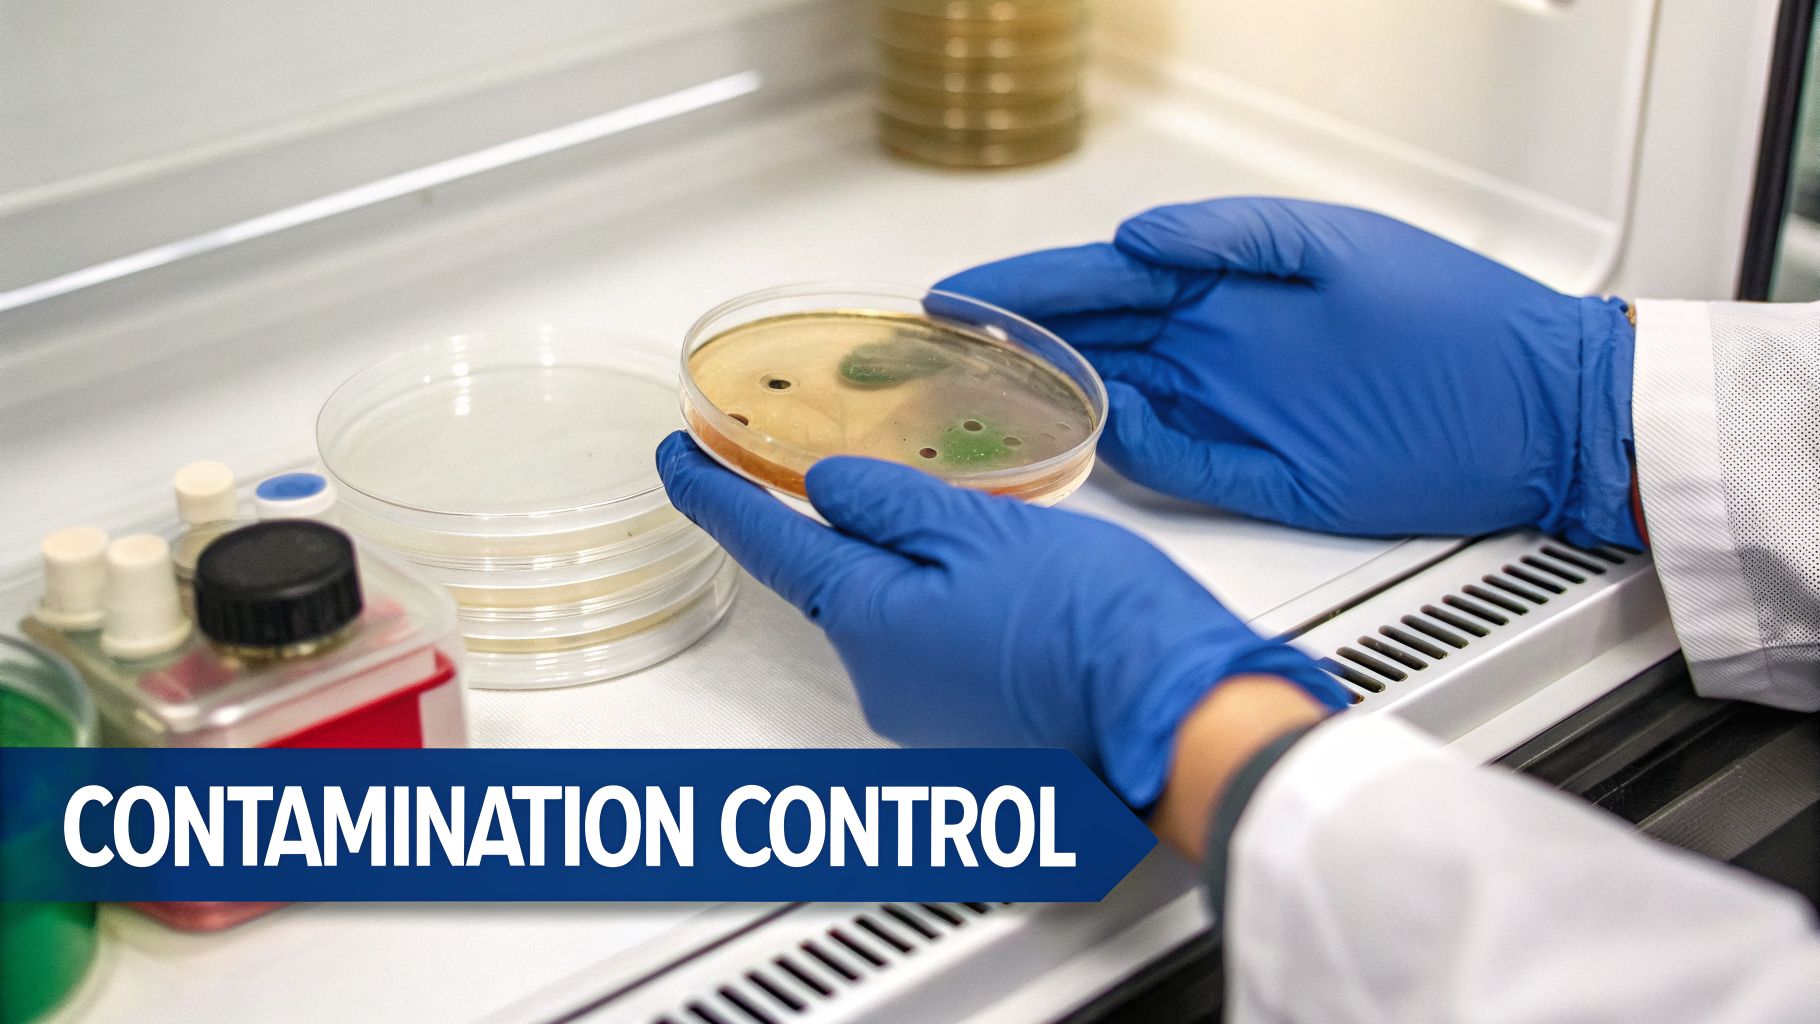
A scientist in blue gloves holds a petri dish showing microbial contamination in a lab.

If you've ever worked in a cell culture lab, you know that the bright pink or red liquid in your flasks isn't just colored water. It’s a meticulously designed, life-sustaining cocktail—a complete nutritional program for cells that have been taken out of their native environment. Getting this 'recipe' right is the absolute foundation of successful research.
Get it wrong, and you're headed for a world of hurt: stressed cells, failed experiments, and data that just doesn't add up. But when you understand what’s in your media and why it’s there, you’re in control. You're laying the groundwork for clean, reliable, and reproducible science.
The Recipe for Life in a Dish
The quality of your media directly dictates the quality of your results, whether you're developing new cell therapies or running basic metabolic assays. Think of it as the difference between feeding your cells a balanced, gourmet meal versus fast food.
This guide will break down the essential components that make up cell culture media. We’ll look at what each ingredient does, why it's critical, and how they all work together to create an environment where your cells can thrive.
First, let's get a bird's-eye view of the main ingredient categories before we dive into the nitty-gritty of each one.
This simple diagram breaks down the thousands of potential ingredients into three core groups: the foundational salts, the essential nutrients, and the specialized supplements. From the simplest inorganic salt to the most complex recombinant growth factor, every single component has a non-negotiable job to do.
Before we explore each category in detail, this table gives you a quick-reference guide to what's in the bottle and what it's doing for your cells.
Quick Guide to Cell Culture Media Components
| Component Category | Primary Function | Example Ingredient |
|---|---|---|
| Inorganic Salts | Maintains osmotic balance and membrane potential | Sodium Chloride (NaCl) |
| Buffering Systems | Regulates and stabilizes pH | Sodium Bicarbonate, HEPES |
| Carbohydrates | Primary cellular energy source | D-Glucose |
| Amino Acids | Building blocks for protein synthesis | L-Glutamine, Leucine |
| Vitamins & Trace Elements | Act as enzyme cofactors in metabolic pathways | Riboflavin, Zinc Sulfate |
| Supplements | Provide growth signals and specialized factors | Fetal Bovine Serum (FBS), EGF |
This table provides a high-level summary, but the real power comes from understanding how these components work in concert to mimic the complex environment inside a living organism.
Core Component Categories
At first glance, a media formulation sheet can look incredibly complex. But it all boils down to a handful of key ingredient groups, each addressing a specific set of cellular needs.
Inorganic Salts: These are the bedrock of any medium. They're not just filler—they are essential for maintaining the correct osmotic pressure, preventing cells from bursting or shriveling. They also provide the ions like sodium, potassium, and calcium that are critical for membrane transport and cell signaling.
Buffering Systems: Cellular metabolism produces waste products (like lactic acid) that can rapidly make the media acidic. A good buffering system is non-negotiable for keeping the pH within a very narrow, life-sustaining range. Without it, your cells would quickly die from stress.
Carbohydrates: This is the fuel. Glucose is the most common energy source, powering everything from basic metabolic activity to cell division.
Amino Acids: If carbohydrates are the fuel, amino acids are the raw materials. They are the fundamental building blocks cells use to construct all the proteins they need to function and replicate.
Vitamins and Trace Elements: These are the unsung heroes. They act as co-factors, helping enzymes do their jobs and ensuring all the intricate metabolic pathways are running smoothly and efficiently.
Supplements: This broad category often includes growth factors, hormones, and, in many traditional formulas, serum. These ingredients provide the specific signals that tell a cell to grow, divide, differentiate, or stay alive.
The importance of these carefully designed mixtures is underscored by the market itself. The global cell culture media market is a multi-billion dollar industry, reflecting its indispensable role in modern biology and medicine.
The financial stakes of getting this recipe right are enormous. Projections show the global cell culture media market, valued at USD 3.02 billion in 2025, is expected to expand to USD 9.86 billion by 2034. This growth is overwhelmingly driven by its critical role in the biotechnology and pharmaceutical industries, which make up over 60% of the market's total use. To see the full breakdown, you can explore the full report on cell culture media growth.
Building the Cellular Environment
Before your cells can get their fuel or building blocks, they need a safe and stable home. The very first step in creating this hospitable setting is establishing the foundational chemistry of the medium. This comes down to two of the most critical components in any cell culture media: inorganic salts and a buffering system.
Think of it like creating a miniature, personalized ocean for your cells. The inorganic salts, like sodium chloride (NaCl) and potassium chloride (KCl), are responsible for getting the "salinity" just right. This is known as osmotic pressure, and it is absolutely vital for cell survival.
Get the salt concentration wrong, and it’s game over. If the media is too dilute, water will rush into your cells, causing them to swell and burst. If it’s too concentrated, water will be pulled out, and they'll shrivel up and die. Maintaining this perfect osmotic balance is non-negotiable for keeping cells intact and functional.
The Role of Inorganic Salts
But salts do more than just manage water balance. The ions they provide—like sodium (Na+), potassium (K+), calcium (Ca2+), and magnesium (Mg2+)—are essential for countless cellular functions that happen every second in your flask.
- Membrane Potential: Ions like Na+ and K+ are constantly pumped across the cell membrane, creating an electrical gradient that’s fundamental for cell signaling and transport.
- Enzyme Cofactors: Ions like Mg2+ act as critical helpers, or cofactors, that allow enzymes to carry out their metabolic jobs correctly.
- Cell Adhesion: For adherent cells, calcium ions (Ca2+) are the glue that helps them attach securely to the surface of the culture flask.
A classic example you'll find in almost any lab is Hank's Balanced Salt Solution (HBSS), which is formulated specifically to provide these crucial ions in a physiologically balanced mix. Getting this base right is the first step to a successful culture.
Keeping The pH Perfectly Stable
Just as important as osmotic pressure is the pH of your culture medium. Cellular metabolism, especially the breakdown of glucose, creates acidic waste products like lactic acid. Without a way to neutralize this acid, the pH would plummet, quickly turning the media into a toxic environment for your cells.
This is where the buffering system comes in. Most cell culture media rely on a bicarbonate-based buffer system (sodium bicarbonate, NaHCO₃) that works in tandem with the carbon dioxide (CO₂) level in your incubator.
The bicarbonate system acts like a chemical sponge, soaking up excess acidity to hold the pH within a razor-thin physiological range—typically between 7.2 and 7.4. A shift of just a few tenths of a point can stop cell growth cold or even trigger mass cell death.
This delicate balance requires precise control over the CO₂ in your incubator, usually set between 5-10%. The CO₂ in the incubator's air dissolves into the medium, reacting with water to form carbonic acid, which then balances with the bicarbonate to lock the pH in place. It's a dynamic, interactive system between your media and your equipment.
The Visual Cue of Phenol Red
So, how do you know if your buffering system is actually working? Thankfully, most commercial media include a brilliant visual indicator: phenol red. This pH-sensitive dye gives you a real-time, at-a-glance reading of your culture’s health.
The color of the media tells a story:
- Optimal pH (7.2-7.4): The media will have a healthy red color.
- Acidic pH (below 6.8): As cells produce metabolic waste and the media becomes acidic, it turns orange and then yellow. This is your cue that it's probably time to change the media.
- Alkaline pH (above 7.8): If the media turns fuchsia or purple, it has become too basic. This often happens if a flask is left outside the CO₂ incubator for too long, allowing CO₂ to escape from the medium.
This simple color change is one of the most valuable tools for daily monitoring, letting you spot and fix problems before they become critical. It's your first line of defense in maintaining that perfect cellular environment.
Fueling the Cellular Engine
Once you've set the stage with the right salts and buffers, it's time to bring in the catering. Your cells are alive, and that means they're hungry. Just like any living thing, they need a constant supply of energy and raw materials to run their internal machinery, grow, and multiply. This is where the core nutritional cell culture media components—carbohydrates, amino acids, and vitamins—come into play.
Think of these three as a team. Carbohydrates are the raw power, amino acids are the construction materials, and vitamins are the foremen who make sure every job gets done right. If any one of them is missing, the entire cellular factory grinds to a halt.
Powering Metabolism with Energy Sources
First things first: cells need fuel. That power is delivered primarily as a simple sugar, glucose.
Think of glucose as the high-octane gasoline for your cellular engine. It's the main carbohydrate in almost every media formulation out there, and for good reason. Cells are masters at breaking down glucose to generate ATP (adenosine triphosphate), the universal energy currency they use to power everything they do.
But glucose isn't always the only fuel in the tank. Many cells, especially fast-growing ones like cancer cells or immune cells, are also incredibly thirsty for L-glutamine. This amino acid pulls double duty, serving as a secondary energy source while also acting as a key building block for other essential molecules.
Glutamine is notoriously unstable in liquid media, breaking down over time into ammonia, which is toxic to cells. This is why many researchers add fresh L-glutamine to their media just before use or opt for more stable dipeptide forms like L-alanyl-L-glutamine to ensure a consistent, reliable supply.
This is why you see media like DMEM offered in high-glucose and low-glucose versions. It lets you match the energy supply to your cell type's specific metabolic appetite. Some sensitive primary cells, for example, actually prefer a low-glucose environment that better mimics their natural conditions in the body.
With a full tank of energy, the cell’s next job is to build and repair itself. That requires a complete set of construction materials.
Assembling Proteins with Amino Acids
If glucose is the fuel, then amino acids are the "Lego bricks" your cells snap together to build proteins. And proteins do everything. They form the cell's physical structure, they run its metabolic reactions, and they carry its signals. Without a full set of these building blocks, protein production stops, and the cell is dead in the water.
Cell culture media absolutely must provide all the essential amino acids—the ones cells can't make themselves. These include famous players like leucine, valine, and methionine. Formulations are painstakingly balanced to provide enough of these for robust growth without creating a toxic overload.
A classic example is RPMI-1640 medium. It was originally designed to grow picky lymphocyte cells in suspension, and its amino acid profile is specifically tailored to meet the massive protein-synthesis demands of these rapidly dividing immune cells. A shortage of even a single amino acid can stress your cells, tank your experiment, and be especially disastrous in something like antibody production, where protein output is the entire point.
Finally, even with fuel and bricks, no project gets very far without good management. That's the vitamins' job.
Facilitating Reactions with Vitamins
Vitamins are the supervisors on the cellular factory floor. They are organic molecules needed in tiny, almost trace, amounts, but their impact is huge. They mainly act as co-factors or co-enzymes—think of them as essential helper molecules that bind to enzymes and switch them "on," allowing them to do their specific chemical jobs.
The B vitamins, for instance, are non-negotiable for energy metabolism:
- Riboflavin (Vitamin B2) is a core part of FAD, a molecule critical for cellular respiration.
- Niacin (Vitamin B3) is used to build NAD, another absolute workhorse in the cell's energy production line.
Without these vitamins, the whole process of turning glucose into ATP becomes incredibly inefficient, if it works at all. A medium like Williams' Medium E, first created for liver cells with their intense metabolic workloads, is packed with a rich variety of vitamins to support these complex functions. Lacking these co-factors creates metabolic bottlenecks, leading to sluggish growth and data you just can't trust.
The Shift Away from Serum
For many years, Fetal Bovine Serum (FBS) was the undisputed workhorse for supplementing cell culture media. It was the all-in-one 'secret sauce'—a complex, undefined cocktail of growth factors, hormones, and proteins that could supercharge almost any cell type. Just a splash of FBS in your basal medium was a simple and remarkably effective way to get your cells growing robustly.
But that reliance on serum came with a heavy price. The biggest headache, by far, is its undefined and variable nature. The exact composition of FBS changes from one batch to the next, a direct reflection of the source animals' health, diet, and even where they lived. This "lot-to-lot variability" is a nightmare for experimental consistency.
This inconsistency makes it nearly impossible to achieve the kind of reproducibility demanded by modern therapeutics and regulatory bodies. On top of that, every batch of serum carries an inherent risk of introducing contaminants like viruses, prions, or mycoplasma—pathogens that can wreck your research and threaten patient safety.
The Rise of Serum-Free and Chemically Defined Media
Faced with these challenges, the scientific community is making a decisive move away from serum. The future of cell culture is in serum-free media and, more specifically, chemically defined media. This isn't just a trend; it's a fundamental requirement for generating reliable, scalable, and safe biological products.
Chemically defined media offer complete control. Every single ingredient is known, and its concentration is precisely measured. This eliminates the black box of serum, providing unparalleled consistency and significantly reducing contamination risks from animal-derived components.
The industry has clearly voted with its feet. Deep-seated concerns over variability and safety have pushed chemically defined formulations to the forefront, now making up 51.0% of the entire cell culture media market. This is especially true in fields like cancer research—which drives 43.4% of all media consumption—where reproducible results are non-negotiable. You can dig deeper into these cell culture media market trends to see the full picture.
Moving to defined formulations also paves the way for cleaner downstream processing and a much smoother conversation with regulatory agencies like the FDA, who insist on well-characterized and consistent manufacturing processes.
Replicating Serum with Targeted Growth Factors
So, how do you replace the potent, growth-promoting magic of serum? The answer is to deconstruct what makes it work and add back only the specific, purified components that truly matter. Instead of pouring in a mysterious mix, scientists now use a precise cocktail of well-understood recombinant proteins and hormones.
Key replacements include:
- Insulin: A powerful promoter for the uptake of glucose and amino acids.
- Transferrin: A protein that acts as a safe delivery vehicle for essential iron.
- Epidermal Growth Factor (EGF): A potent signaling molecule that stimulates cell proliferation.
- Fibroblast Growth Factor (FGF): Critical for the growth and differentiation of many cell types, especially stem cells.
By adding a carefully crafted blend of these and other specific factors, researchers can deliver targeted signals that command cells to grow, divide, or differentiate in highly predictable ways. This is a level of control that serum simply can't offer.
Comparing Serum-Containing vs Chemically Defined Media
Choosing between a traditional, serum-spiked medium and a modern, chemically defined one involves a clear trade-off. While serum is often easy to use and can get a wide range of cells to grow, chemically defined media deliver the consistency and safety that advanced applications demand. This table breaks down the key differences to help guide your decision.
| Feature | Serum-Containing Media | Chemically Defined Media |
|---|---|---|
| Composition | Undefined; contains unknown factors. | Every component is known and quantified. |
| Consistency | High lot-to-lot variability. | Excellent lot-to-lot consistency. |
| Contamination Risk | Higher risk of viral or prion contamination. | Minimal risk; free of animal-derived components. |
| Reproducibility | Lower; results can vary between batches. | High; enables reproducible experiments. |
| Regulatory Path | More complex due to undefined nature. | Simplified; favored for therapeutic production. |
| Optimization | Difficult to optimize; "black box" approach. | Allows for systematic optimization of components. |
Ultimately, the shift toward serum-free and chemically defined media is all about gaining control. It’s about moving from an empirical, "it just works" approach to a rational, data-driven one that delivers the predictable and scalable results demanded by today's scientific and biomanufacturing standards.
Protecting Your Cultures from Contamination
You’ve spent all this time crafting the perfect nutritional recipe for your cells. Nothing—and I mean nothing—will derail your research faster than contamination.
A single stray bacterium or fungal spore can turn your nutrient-rich media into a playground for microbes, torching weeks of work in the blink of an eye. Protecting your cultures isn’t just a step in the process; it’s a non-negotiable part of good cell culture practice that starts long before you add a single drop of antibiotic.
The first and most critical line of defense is always a rock-solid aseptic technique. This means working in a biological safety cabinet, sterilizing every piece of equipment, and handling your flasks with the care of a bomb disposal expert.
To truly safeguard your valuable cells from airborne threats and maintain a sterile environment, you need more than just good habits. Advanced filtration systems like HEPA air filter machines are crucial for ensuring the clean air your sterile technique depends on.
But let's be realistic. Even with the most disciplined technique, contaminants can sometimes slip through. This is where antibiotics and antimycotics enter the picture, but they must be viewed as a last-resort safety net, not a crutch.
Antibiotics as a Last Line of Defense
Many labs, out of habit, routinely dump an antibiotic-antimycotic solution—most commonly Pen-Strep (Penicillin-Streptomycin)—into their media. It feels like an easy insurance policy.
Penicillin works by hammering the cell wall synthesis of Gram-positive bacteria, while streptomycin goes after protein synthesis in Gram-negative bacteria. Together, they offer broad-spectrum protection against common bacterial invaders.
But relying on them is a dangerous habit. Antibiotics can mask low-level, chronic infections that don't cause obvious cloudiness but still quietly alter cell metabolism and completely skew your experimental data. Worse, their continuous use can breed antibiotic-resistant superbugs in your own lab.
Key Takeaway: Antibiotics should never, ever be a substitute for good aseptic technique. Use them for short-term protection, like when you're establishing a new primary culture, but get them out of there once the culture is stable and confirmed clean.
Beyond the threats you can see, like bacteria and fungi, lies a far more insidious enemy. It’s an invisible saboteur, and it’s a major headache for every cell culture lab on the planet.
The Invisible Enemy: Mycoplasma
Mycoplasma. The word alone is enough to send a shiver down a cell biologist’s spine. These are a genus of tiny bacteria that have no cell wall, a trait that makes them completely resistant to common antibiotics like penicillin.
They are a frequent, frustrating, and deeply problematic contaminant. Some studies estimate that a staggering 15-35% of all continuous cell lines are currently infected.
What makes mycoplasma so destructive is its stealth. A typical bacterial infection makes your media cloudy and yellow, screaming for attention. A mycoplasma infection is visually undetectable. The media looks perfect, the pH is stable, yet these organisms are silently hijacking your cells and feasting on their resources.
They compete for essential nutrients, warp gene expression, and throw normal cell metabolism into chaos, leading to data that is unreliable and impossible to reproduce. Because you can't see it, you could unknowingly publish data from infected cells, compromising the integrity of your work and the scientific record.
For this reason, routine screening for mycoplasma is absolutely essential.
Best practices are non-negotiable:
- Regular Testing: Test every new cell line the moment it arrives and then re-test on a monthly or quarterly basis. No exceptions.
- Isolate New Cells: Quarantine any new cell lines you receive from other labs or collaborators until they have been tested and confirmed to be negative.
- Use Reliable Detection Methods: PCR-based kits or specialized fluorescent stains are the gold standard. They are sensitive, specific, and will catch what your eyes can't.
Protecting your work means being vigilant against all threats, both seen and unseen. By combining militant sterile technique with the strategic (and temporary) use of antibiotics and, most importantly, routine mycoplasma testing, you can safeguard your cultures and ensure the integrity of your hard-earned data.
With hundreds of unique formulations on the market, picking the right cell culture medium can feel like a shot in the dark. But once you understand what each component does, you can move past just grabbing the lab’s default bottle and start making a strategic choice.
The right medium isn’t just about keeping your cells alive. It’s about creating an environment where they produce reliable, meaningful data. It all boils down to answering a few straightforward questions. Doing so will cut through the noise, narrowing a field of hundreds down to just a handful of solid options.
What Is Your Cell Type?
This is where everything starts. Every cell type has a unique set of nutritional requirements shaped by its tissue of origin and biological role. A tough, fast-growing cancer cell line has a completely different metabolic appetite than a delicate, slow-growing primary neuron.
- Adherent vs. Suspension: Do your cells need to anchor to a surface to grow, or are they happy floating in suspension? This is one of the first and most fundamental dividing lines between media formulations.
- Metabolic Rate: A cell line with a high metabolic rate, like a HeLa cell, will burn through glucose and might thrive in a rich formulation. In contrast, a more sensitive primary cell might perform better in a low-glucose environment that better mimics its natural in vivo state.
A perfect illustration of this is the difference between DMEM and RPMI-1640, two of the most common basal media you'll find in any lab.
DMEM (Dulbecco's Modified Eagle Medium) is the workhorse for many robust, adherent cells like fibroblasts and endothelial cells. It’s loaded with amino acids and vitamins to fuel vigorous growth. RPMI-1640, on the other hand, was formulated specifically for human leukemia cells growing in suspension and has a chemical makeup tailored for non-adherent lymphoid cells.
What Is Your Research Goal?
Your end game is just as important as your cell type. The demands of a basic academic discovery experiment are worlds away from those of developing a process for large-scale bioproduction.
For routine cell maintenance or basic research, a classic, serum-supplemented medium is often perfectly fine—and it’s usually the most cost-effective option. But if your work involves biomanufacturing therapeutic proteins or developing a cell therapy product, the path gets much, much narrower.
In these cases, regulatory compliance is everything. You will almost certainly need a serum-free or, even better, a chemically defined formulation. Using a medium where every single component is known and quantified is non-negotiable for ensuring the batch-to-batch consistency and safety demanded by regulatory agencies. This completely removes the "black box" of variability that comes with serum and gives you a clean, reproducible process.
Ultimately, choosing the right medium means matching the formulation to your biological system and your end goal. By asking these two key questions—what are my cells, and what am I trying to do?—you turn media selection from a guessing game into a strategic decision that sets your research up for success.
Common Questions from the Bench: A Practical Media FAQ
Even with a solid understanding of media components, the day-to-day reality of cell culture always throws a few curveballs. Here are some of the most common questions we hear from researchers in the trenches, with practical answers to help you troubleshoot what you're seeing in the flask.
How Often Should I Change My Media?
There’s no universal schedule—it all comes down to your specific cells and their density. The classic rule of thumb is every 2-3 days.
But your cells will tell you when they need it. The most obvious signal is the phenol red indicator. If your media has turned yellow, it's a sign that metabolic waste has made it too acidic. It needs to be changed immediately. Fast-growing cultures at high density might need fresh media every single day, while slower, sparser cultures can often go a bit longer.
Why Did My Media Suddenly Turn Bright Purple?
A fuchsia or deep purple color means your media has become too alkaline, usually pushing the pH above 7.8. Nine times out of ten, this happens for one simple reason: the flask was left outside the CO₂ incubator for too long.
The bicarbonate buffering system in your media is in a delicate equilibrium with the 5% CO₂ atmosphere inside the incubator. When you take the flask out, that CO₂ escapes from the media into the open air, causing the pH to shoot up. The fix is simple: make sure your flasks have vented caps to allow for gas exchange and get them back into the incubator promptly.
A sudden color change can also be a red flag for contamination. If the pH shifts dramatically without an obvious cause—like being left on the bench—it’s smart to take a close look under the microscope for microbial growth, even if the media isn't cloudy.
Is It Worth Making My Own Media from Powder?
Technically, you can. But it’s a meticulous, time-consuming, and contamination-prone process that most modern labs have moved away from.
Commercial, sterile-filtered liquid media offers a massive advantage in quality control and consistency. For the vast majority of labs, the time you save and the batch-to-batch reliability you gain make purchasing ready-to-use cell culture media components the only practical choice. It's about building your experiments on a foundation you can trust.
At PurMa Biologics, we provide thousands of high-quality, pre-formulated media and reagents to ensure your research is built on a foundation of consistency and reliability. Explore our extensive catalog of cell culture solutions to find the perfect formulation for your specific needs.